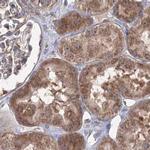
PEX13 Antibody in Immunohistochemistry (IHC)

Search
Invitrogen
PEX13 Polyclonal Antibody
{{$productOrderCtrl.translations['antibody.pdp.commerceCard.promotion.promotions']}}
{{$productOrderCtrl.translations['antibody.pdp.commerceCard.promotion.viewpromo']}}
{{$productOrderCtrl.translations['antibody.pdp.commerceCard.promotion.promocode']}}: {{promo.promoCode}} {{promo.promoTitle}} {{promo.promoDescription}}. {{$productOrderCtrl.translations['antibody.pdp.commerceCard.promotion.learnmore']}}

Please note: We are reviewing Western blot images included in the antibody testing data in our catalog, including those provided by third parties. Unless expressly labeled or annotated as “raw-unedited”, Western blot images included in the antibody testing data in our catalog may have been edited, optimized or otherwise adjusted for presentation.
产品信息
PA5-56941
种属反应
宿主/亚型
分类
类型
抗原
偶联物
形式
浓度
规格
纯化类型
保存液
内含物
保存条件
运输条件
RRID
产品详细信息
Immunogen sequence: GLIPANYVKI LGKRKGRKTV ESSKVSKQQQ SFTNPTLTKG ATVADSLDEQ EAAFESVFVE TNKVPVAPDS IGKDG
Highest antigen sequence identity to the following orthologs: Mouse - 80%, Rat - 79%.
靶标信息
PEX13 (Peroxisomal Biogenesis Factor 13) is a gene located on chromosome 2p15 that encodes a peroxisomal membrane protein essential for the biogenesis and function of peroxisomes, which are cellular organelles involved in lipid metabolism and detoxification of reactive oxygen species. PEX13 is a component of the peroxisomal import machinery that specifically recognizes and binds to peroxisomal targeting signal 1 (PTS1) containing proteins, facilitating their import into the peroxisome matrix. Mutations in the PEX13 gene can lead to Zellweger spectrum disorders, a group of peroxisome biogenesis disorders (PBDs) characterized by defects in multiple peroxisomal metabolic pathways, leading to severe developmental issues, neurological deficits, and often early lethality. Studies of PEX13 have helped elucidate the mechanisms of peroxisomal protein import and the broader implications of peroxisomal dysfunction in human disease.
仅用于科研。不用于诊断过程。未经明确授权不得转售。




